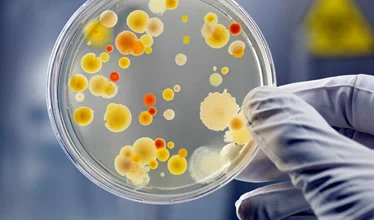
….Jakkes microben ..Ugh microbes ….

….Jakkes microben ..Ugh microbes ….
....
Een ecosysteem in ons ecosysteem?
Zo ontzettend lang hebben we die kleine organismen in onze buik genegeerd, recente onderzoeken hebben echter de belangrijke rol van het microbioom in de menselijke gezondheid en ziekte aangetoond.
Wat zijn microben, onze microbiota en het menselijk microbioom nu precies?
- Microben: een microbe, of 'microscopisch organisme', is een levend iets dat te klein is om met het blote oog te worden gezien. De term is heel algemeen. Het wordt gebruikt om veel verschillende soorten levensvormen te beschrijven, met dramatisch verschillende groottes en kenmerken: bacteriën, archaea, schimmels, protisten, virussen en microscopische dieren. Het menselijk lichaam is de thuisbasis van microben uit al deze categorieën.
- Microbiota: een verzameling of gemeenschap van microben.
- Microbioom: sommigen gebruiken "microbioom" om alle microben in een gemeenschap aan te geven. Wij, en anderen gebruiken, het om de volledige verzameling genen van alle microben in een gemeenschap te benoemen, ons menselijk ecosysteem. Het humane microbioom (alle genen van onze microben) kan worden beschouwd als een tegenhanger van het menselijke genoom (al onze genen). De genen in ons microbioom overtreffen de genen in ons genoom met ongeveer 100 tegen 1.
Microben werken samen in gemeenschappen en reageren op hun omgeving. Net als organismen in de ecosystemen van de aarde verschuiven onze microbiële populaties wanneer hun omgeving verandert. Een paar microben veroorzaken ziekte, maar de meesten niet. In feite zijn vele essentieel voor een goede gezondheid. Het verstoren van onze microbiële ecosystemen kan ziekten veroorzaken en sommige ziekten verstoren onze microbiële ecosystemen weer op hun beurt.
- Dieet: wat we eten verandert ons microbioom sneller dan verwacht.
- Diabetes: ons microbioom is geassocieerd met diabetes type II en de complicaties die daarmee gepaard gaan.
- Obesitas: obesitas, metabool syndroom en gastro-intestinale aandoeningen worden allemaal beïnvloed door ons darmmicrobioom.
- Geestelijke gezondheid: van ons darmmicrobioom is aangetoond dat het depressie, cognitie, gedrag en neurale ontwikkeling beïnvloedt.
- Auto-immuunziekte: ons microbioom beheert ons immuunsysteem meer dan we ons realiseren.
- Dikkedarmkanker: verschuivingen in de samenstelling van ons darmbiobioom worden geassocieerd met colorectale kanker.
- Ziekte van Parkinson: darmflora is in verband gebracht met de ziekte van Parkinson en de motorische symptomen ervan.
- Hartaandoeningen: bepaalde bacteriën zijn in verband gebracht met atherosclerose, een veel voorkomende hartaandoening.
- Ziekte van Alzheimer: microben zijn betrokken bij de ontwikkeling van de ziekte van Alzheimer.
En nog veel meer. Zorg dus goed voor die kleine vriendjes in uw binnenste en ze zullen op hun beurt voor u zorgen.
..
An ecosystem in our ecosystem?
For so long we have ignored those little organisms inside our gut, recent research has demonstrated the microbiome’s significant role in human health and disease.
What exactly are microbes, our microbiota, and the human microbiome?
- Microbes: A microbe, or “microscopic organism,” is a living thing that is too small to be seen with the naked eye. The term is very general. It is used to describe many different types of life forms, with dramatically different sizes and characteristics: bacteria, archaea, fungi, protists, viruses and microscopic animals. The human body is home to microbes from all of these categories.
- Microbiota: A collection or community of microbes.
- Microbiome: Some use “microbiome” to mean all the microbes in a community. We and others use it to mean the full collection of genes of all the microbes in a community, our human ecosystem. The human microbiome (all of our microbes’ genes) can be considered a counterpart to the human genome (all of our genes). The genes in our microbiome outnumber the genes in our genome by about 100 to 1.
Microbes interact in communities, and they respond to their surroundings. Just like organisms in Earth’s ecosystems, our microbial populations shift when their environment changes. A few microbes cause disease, but most do not. In fact, many are essential for good health. Disrupting our microbial ecosystems can cause disease, and some diseases disrupt our microbial ecosystems.
- Diet: What we eat alters our microbiome faster than expected.
- Diabetes: Our microbiome is associated with both type II diabetes and the complications that come with it.
- Obesity: Obesity, metabolic syndrome and gastrointestinal disease are all influenced by our gut microbiome.
- Mental health: Our gut microbiome has been shown to influence depression, cognition, behavior, and neural development.
- Autoimmune disease: Our microbiome controls our immune system more than we realize.
- Colorectal cancer: Shifts in the makeup of our gut microbiome are associated with colorectal cancer.
- Parkinson’s disease: Gut microbiota have been linked to Parkinson’s disease and its motor symptoms.
- Heart disease: Certain bacteria have been linked to atherosclerosis, an all-too-common heart condition.
- Alzheimer’s disease: Microbes are involved in the development of Alzheimer’s pathology.
And many more. Take good care of those little friends inside your gut and they’ll in turn will take care of you.
....